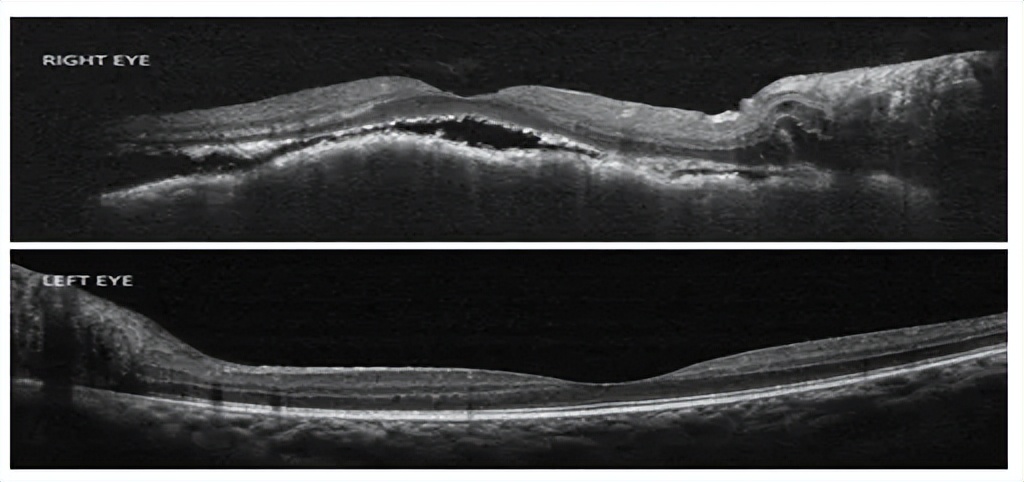

编者按
恶性肿瘤的转移是一个极其复杂且多变的过程,具有广泛的侵袭性,人体各个部位均有可能受到累及。眼部作为人体重要的感官器官,虽然在肿瘤转移中并非常见靶点,但一旦受到肿瘤侵袭,由于其独特的解剖结构和多样的临床表现,往往会给疾病的诊断与治疗带来重重挑战。脉络膜转移癌,作为恶性肿瘤眼部转移的一种特殊类型,因其临床表现的隐匿性及易于误诊的特点,常致患者错失最佳的治疗窗口。而肺腺癌,作为众多原发肿瘤中的“常客”,其以脉络膜转移作为首发表现的病例更是极为罕见。特别是这类罕见病例发生在年轻、非吸烟且无肿瘤家族史的个体上时,无疑为临床诊疗工作增添了前所未有的难度与复杂性。

患者为一名29岁女性,无吸烟史及肿瘤家族史,主诉右眼视力下降3周。
眼科检查
视力:右眼最佳矫正视力(BCVA)为指数视力,左眼20/20。
眼压:双眼均为18 mmHg。
前节检查:双眼无异常。
眼底检查:右眼颞下动脉弓下方可见一个约3个视盘面积大小的黄橙色脉络膜肿物,伴有周围渗出性视网膜脱离。

荧光素眼底血管造影和吲哚青绿眼底血管造影:早期弥漫性强荧光,随时间荧光强度递增,符合肉芽肿性病变特征。

光学相干断层扫描:右眼黄斑区存在视网膜下积液伴渗出性沉积物。
全身评估
血液检查:正常。
胸部X线:右肺中下叶均匀致密阴影,伴有胸腔积液及下方塌陷。

CT血管造影:纵隔及右肺门淋巴结肿大伴中央坏死性病变,并致左、右上肺静脉狭窄。双侧肾脏皮质、肝左叶及右侧肾上腺可见多发低密度病灶。


右侧下气管旁淋巴结细针穿刺检查显示:在出血背景中可见散在重叠的异型性上皮细胞团,免疫组化呈阳性反应。
最终诊断
中分化肺腺癌(IV期)伴淋巴结转移 (纵隔、右锁骨上、腹膜后上部)、肝脏、右肾上腺、多发性骨转移及脑转移。
小结
脉络膜转移作为肺腺癌的首发表现,在临床上极为罕见。本病例中的患者是一位29岁的非吸烟女性,且无肿瘤家族史,这一背景在肺部肿瘤患者中尤为不常见。该患者出现的单侧脉络膜转移症状,更是非典型表现,目前文献中尚未有年轻女性肺部肿瘤患者呈现此类症状的报道。此病例的发现,不仅拓宽了我们对肺腺癌转移模式的认识,也为眼科与肿瘤科医师提供了新的诊断视角。它提醒我们,在面对不明原因的脉络膜病变时,应高度警惕全身肿瘤的可能性,以免漏诊误诊。
讲题:Unilateral choroidal granuloma:A Masquerade
作者:Bhuvan Chanana